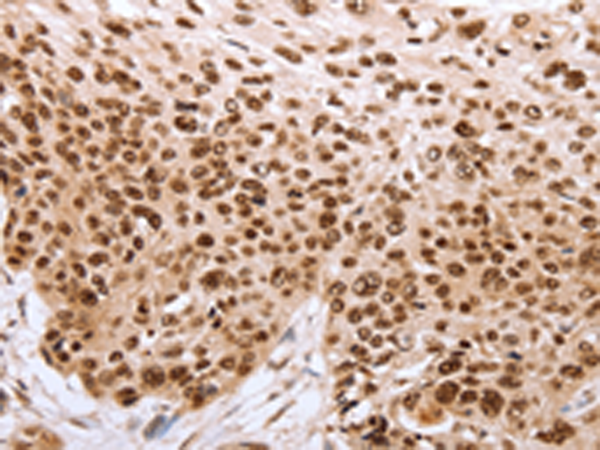

-
分类: 科研抗体货号: P11309别名: 7B4, CD144应用: IHC反应种属: Human
-
分类: 科研抗体货号: P11288别名: IMF2; LMNS; CASIL; CADASIL; CADASIL1应用: WB,IHC反应种属: Human, Mouse, Rat
-
分类: 科研抗体货号: P11308别名: PARP, PPOL, ADPRT, ARTD1, ADPRT1, PARP-1, ADPRT 1, pADPRT-1应用: WB,IHC反应种属: Human, Mouse, Rat
-
分类: 科研抗体货号: P11287别名: hN2; AGS2; HJCYS应用: WB,IHC反应种属: Human, Mouse, Rat
-
分类: 科研抗体货号: P11307别名: PAP2; PRG5; LPPR5; PAP2D应用: WB,IHC反应种属: Human, Mouse
-
分类: 科研抗体货号: P11286别名: hN1; AOS5; TAN1; AOVD1应用: WB,IHC反应种属: Human, Rat
-
分类: 科研抗体货号: P11305别名: HSD-PLA2应用: WB,IHC反应种属: Human, Mouse, Rat
-
分类: 科研抗体货号: P11285别名: OOR, ORL1, KOR-3, NOCIR应用: WB反应种属: Human, Mouse, Rat
-
分类: 科研抗体货号: P11304别名: FANCN; PNCA3应用: WB,IHC反应种属: Human, Mouse
-
分类: 科研抗体货号: P11284别名: SKR, NK2R, NKNAR, TAC2R应用: WB,IHC反应种属: Human

鄂公网安备42018502007531号
鄂公网安备42018502007531号

